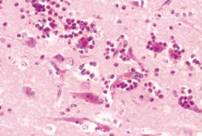
Water salt posionoing eosinophilia meningeoencephalitis spb

Pulmonary Oedema
Pulmonary oedema is a pathological response to a wide range of clinical situations.
This advice sheet illustrates some of the major problems where pulmonary oedema may be seen
|
Cardiac insufficiency - hydrostatic |
||||
|
Left ventricular failure – pulmonary oedema Right ventricular failure – generalised oedema |
||||
|
Heart
failure - PCV2
or Encephalomyocarditis virus.
Cardiotoxins – chronic Gossypol
poisoning |
||||
|
|
|
|
||
|
Pulmonary
oedema in PCVAD |
Rounded heart
seen in fresh carcase not so obvious once rigor mortis has set in |
Note lungs
are generally IHC PCV2 negative |
||
|
|
|
|
||
|
Endocarditis
– Erysipelas
or Streptococcus
suis. Pictures show
pig with endocraditis – blue ears, lesions on heart valves and pulmonary
oedema |
||||
|
|
|
|
||
|
Pericarditis
with associated pulmonary oedema |
Mulberry heart disease – Vit E
Association
with Linoleotic and fish oils |
Chronic anaemia
– chronic
gastric ulcer or even severe lice infestation |
||
|
|
|
|
||
|
Low blood osmotic pressure |
||||
|
|
|
|
||
|
Liver disease
– Stephanurus dentatus
in adults or liver abscess |
Nephrotic syndromes
– Glomerular nephritis in PDNS for example |
Protein
losing enteropathy – severe necrotic
enteritis and colitis
|
||
|
|
|
|
||
|
Haemorrhagic
shock – acute gastric ulcer. Oedema can be seen in neonates with naval
bleeding. |
Areas of pulmonary
oedema in a case of Haemorrhagic bowel syndrome |
Anticoagulants
– the lungs above are from a pig with a congenital blood clotting problem |
||
|
|
|
|
||
|
Permeability oedema (inflammation) |
||||
|
|
|
|
||
|
Bacterial toxins
– DIC – endotoxins from gram –ve bacteria – Salmonella
classic |
Kidney
changes with DIC – coagulative necrosis of the glomerulus |
Pulmonary
oedema in DIC |
||
|
|
|
|
||
|
Smoke
inhalation |
Toxins – Fumonisin
>25 ppm Ammonia high
concentrations Organophosphate
poisoning |
Diaphragmatic
hernia – lung torsion |
||
|
|
|
|
||
|
Neurogenic pulmonary oedema |
||||
|
|
|
|
||
|
Water
deprivation – salt poisoning – eosinophilic meningoencephalitis |
E. coli oedema disease – note swollen eyelids and expression |
|
||
|
Acute respiratory disease syndrome – ARDS |
||
|
Sepsis – note all pulmonary oedema looks alike – the clinician needs to see what other pathological lesions are present |
||
|
|
|
|
|
Complicated enzootic
pneumonia |
Bacterial and
viral pneumonia PRRSv,
Influenza and pasteurella – Mycoplasma
hyopneumoniae free |
Clostridium septicum infection with resultant
pulmonary oedema |
|
|
|
|
|
Actinobacillus
pleuropneumona associated pulmonary oedema |
Bordetella bronchiseptica pneumonia |
Pulmonary
oedema in a case of Glässer’s disease |
|
Pathogens where pulmonary oedema may be seen in some of the disease presentations: |
||
|
Clostridium septicum |
||
|
|
|
|
|
Cytomegalovirus |
||
|
Encephalomyocarditis
virus |
||
|
Enterovirus |
|
|
|
|
|
|
|
Aspiration of
gastric contents |
Pancreatitis |
PSS – Dead in
transit Slaughterhouse/death
stress |